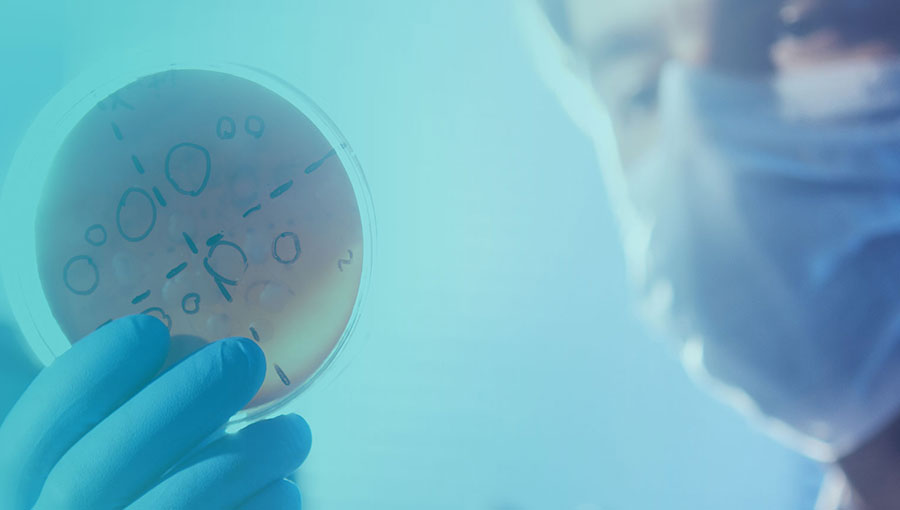

中國質量檢驗協會是由質量檢驗領域的相關技術機構和專家學者、工作者,相關科研院所、大專院校、學術機構,與質量檢驗有關的企事業單位及相關負責人、社會各界人士等自愿結成的全國性、行業性社會團體,登記機關為民政部,行業管理部門為市場監管總局。
按照“服務會員,服務企業,服務政府,服務社會,服務消費,服務發展”的工作原則,貫徹“精業篤行,守正創新,團結協作,開拓進取”的工作精神,恪守“實事求是,尊重人才,創新興會,服務立會”的工作風尚,落實“專業引領、學術研究,政策咨詢、決策參考,科技普及、質量引領,信任傳遞、助力發展”的工作任務,遵循“質量檢驗、客觀公正,規范市場、扶優治劣,服務企業、引導消費”的工作方向,堅持“專業化,技術化,社會化,服務化”的發展目標,引導各級質量檢驗機構發展壯大和行業自律,發揮政府和企業、行業之間的橋梁紐帶作用,對產品質量、服務質量和工程質量進行社會監督,督促和引導企業積極參與質量提升行動、推進品牌建設;營造公平競爭的市場環境,激發各類市場主體的質量發展潛力,不斷增強人民對質量的獲得感、幸福感和安全感。本團體是相關政府主管部門聯系質量檢驗行業、質量領域科技工作者和專家學者、廣大企業及社會各界的橋梁和紐帶,是質量發展與質量檢驗工作的重要組成部分,是推動質量發展與質量檢驗行業高質量發展及質量提升推進、質量強國事業建設的重要社會力量。
充分發揮質量專業社團組織的中介作用,以習近平新時代中國特色社會主義思想為指導,完整、準確、全面貫徹新發展理念,加快構建新發展格局,全面深化改革開放,堅持創新驅動發展,推動高質量發展,堅持以供給側結構性改革為主線,以滿足人民群眾日益增長的美好生活需要為根本目的,宣傳貫徹質量領域的法律、法規、政策,組織質量和質量檢驗方面的標準研究、制定和技術開發,開展質量和質量檢驗方面的學術交流、技術培訓和相關技術咨詢與技術服務;切實發揮“質量檢驗,客觀公正,服務企業,引導消費”的社會監督作用,抓好質量提升;精業篤行,扶優治劣,充分利用全國各省(自治區、直轄市)質檢院(所)和重點國家級質檢中心與相關質檢機構等副會長、常務理事、理事單位和技術機構會員單位的專業優勢,組織開展“3.15”“質量月”等質量誠信主題(專題)宣傳活動,對“全國質量檢驗穩定合格產品”進行調查匯總和展示公告,推廣防偽溯源和質量誠信驗證等技術應用,傳遞質量信任,引導質量消費,維護市場公平競爭,營造良好市場環境,加強市場引導,共筑質量誠信,推動質量社會共治共享;組織新技術、新產品鑒定和評審,對產品質量、服務質量、工程質量開展檢驗、鑒定、監理方面的咨詢和服務;樹立質量工作先進典型和質量誠信標桿,弘揚工匠精神,推廣質量工作優秀示范的先進經驗;承辦有關政府部門(機構)交辦和委托的相關工作;著力發揮全國質量檢驗行業組織的橋梁紐帶作用,科學求實,開拓創新,全面引領質量檢驗行業自律和健康發展;履行質量專業社團中介機構的相關職能,激發市場主體活力,大力開展質量提升行動,督促企業履行質量主體責任,助力企業高質量發展,助推產業轉型升級,大力營造“政府重視質量、企業追求質量、社會崇尚質量、人人關心質量”的濃厚氛圍,合力推進質量社會共治,扎實推進質量強國建設。
(一)持續推進“三個轉變”重要思想,助力提高中國質量國際影響力和國際競爭力,為中國質量走向世界提供服務,發揮質量檢驗對提升國家核心競爭力的重要作用,為我國經濟社會全面、協調、可持續健康發展服務;
(二)圍繞質量發展與質量檢驗能力水平的提升和質量事業的整體發展開展相應的學術研究,推進行業交流,促進行業發展,助力“黨委領導,政府主導,部門聯合,企業主責,社會參與”的質量工作格局,為構建新時代質量檢驗能力提升與產品和服務質量提升及質量發展新局面提供技術支撐和專業保障;
(三)緊緊圍繞質量提升、質量發展工作大局和實施質量強國戰略與質量檢驗行業建設,開展質量提升、質量發展與變革創新等調查研究,建立全國性的質量檢驗和質量發展學術交流、科普宣傳和技術服務平臺;
(四)加強質量檢驗與質量發展相關的理論研究,提高質量檢驗和質量發展研究的針對性、協同性、規范性和有效性,促進質量工作隊伍成長和質量檢驗行業能力提升;
(五)受政府委托承辦或根據市場和行業發展需要,開展質量檢驗和質量發展與質量工作的宣傳、咨詢、培訓和展覽展示等活動,推廣普及質量檢驗與質量知識,宣傳貫徹質量法律法規、方針政策,宣傳質量檢驗與質量工作在社會經濟發展中的重要作用,發揮社會監督作用,推進質量社會共治;
(六)推動質量檢驗和質量提升與質量發展戰略的研究及學術交流,依照有關規定組織出版本團體學術性會刊及有關學術性、科普性刊物和書籍資料,為政府、社會和企業提供有關咨詢服務與專業支持;拓寬輿論傳播途徑,建設本團體官方網站和相關業務網站;
(七)推行先進的質量檢驗檢測和質量管理方法,開展檢驗檢測能力與質量管理科學技術、方法提升的相關活動,提高質量檢驗、質量管理創新能力和全民質量意識;
(八)探索質量檢驗、質量管理理論和實踐的研究,總結推廣質量檢驗和質量管理經驗,開展質量檢驗、質量管理和質量提升、質量發展與質量溯源、防偽驗證等方面的技術咨詢和服務與推廣,促進科技成果轉化;
(九)引導企業開展質量提升行動,支持企業做好質量基礎工作,督促企業加強信用建設,推進企業重視品牌建設,促進企業注重質量發展意識并切實提高質量檢驗能力和質量控制水平,著力提升產品和服務質量;
(十)經政府有關部門批準,對產品質量、服務質量以及工程質量開展多種形式的比較試驗、綜合評價、體驗式調查和第三方檢驗、鑒定、評估和監理,引導理性消費選擇;
(十一)對損害本團體會員品牌和質量聲譽的違法違規行為進行輿論監督;收集和反饋本團體會員和質量檢驗與質量工作者的建議、意見和訴求,關心和維護質量檢驗與質量工作者的合法權益,為本團體會員和質量檢驗與質量工作者提供廣泛的專業服務活動;
(十二)開展質量檢驗和質量學風評議工作,加強質量檢驗行業和質量發展研究領域學風與學術道德建設;
(十三)推動開展對本團體會員和質量政策法規與檢驗檢測領域科技研究及實踐運用工作者的考試及繼續教育培訓工作,興辦符合本團體宗旨并能夠為本團體會員和質量發展事業與檢驗檢測行業建設發展服務的事業及相關經濟實體;
(十四)開展企業質量檢驗機構的評審,開展質量評估和推廣質量保險業務,利用各種方式向消費者提供質量信息,宣傳和普及質量知識和消費常識,傳遞質量信任、引導質量消費,為市場、企業和消費者服務,切實維護社會各界的合法權益;
(十五)組織開展質量檢驗技術、儀器設備、檢驗設施和質量檢驗標準等方面的研究、開發、咨詢、服務,經政府有關部門批準,組織對其進行鑒定、評審和推廣應用;
(十六)參與質量檢驗檢測和質量管理、質量發展相關領域國家標準和行業標準的制修訂與實施工作,并積極組織開展相關領域團體標準的制修訂和實施工作,助力改革完善質量標準體系;
(十七)在業務主管單位和相關主管部門的指導下開展國際交流合作,加強本團體與境外質量檢驗和質量領域學術組織及質檢機構與相關組織建立友好往來與交流合作關系,促進質量檢驗和質量工作與國際慣例接軌,拓展本團體國際合作的視野和平臺,服務和推動中國質量、中國標準、中國品牌走向世界;
(十八)承擔相關部門委托的質量提升、質量管理、質量發展與質量檢驗相關的有關工作。
中國質量檢驗協會籌備于1986年,并于1992年正式成立,登記管理機關為民政部,行業主要管理部門為國家市場監督管理總局(簡稱國家市場監管總局),在行業主要管理部門的對口司局為國家市場監管總局質量發展局(牽頭對口司局)、國家市場監管總局認可檢測司。國家市場監管總局2018年4月組建成立之前,中國質量檢驗協會歷任業務主管部門為原國家質量監督檢驗檢疫總局(簡稱原國家質檢總局)、原國家質量技術監督局、原國家技術監督局、原國家經濟委員會質量局。

京公網安備 11010502043458號
京公網安備 11010502043458號